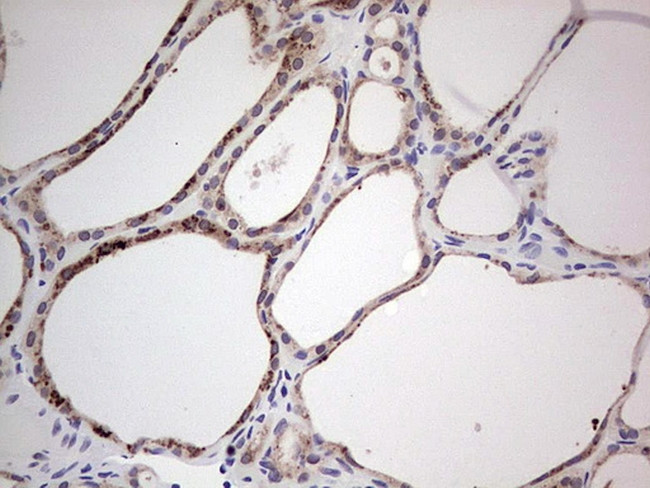
HDAC9 Antibody in Immunohistochemistry (Paraffin) (IHC (P))

Search
OriGene
HDAC9 Monoclonal Antibody (OTI6E2), TrueMAB™
{{$productOrderCtrl.translations['antibody.pdp.commerceCard.promotion.promotions']}}
{{$productOrderCtrl.translations['antibody.pdp.commerceCard.promotion.viewpromo']}}
{{$productOrderCtrl.translations['antibody.pdp.commerceCard.promotion.promocode']}}: {{promo.promoCode}} {{promo.promoTitle}} {{promo.promoDescription}}. {{$productOrderCtrl.translations['antibody.pdp.commerceCard.promotion.learnmore']}}
产品信息
CF805257
种属反应
宿主/亚型
分类
类型
克隆号
抗原
偶联物
形式
浓度
纯化类型
保存液
内含物
保存条件
运输条件
产品详细信息
For reconstitution, we recommend adding 100 µL distilled water to a final antibody concentration of about 1 mg/mL. To use this carrier-free antibody for conjugation experiments, we strongly recommend performing another round of desalting. (Zeba Spin Desalting Columns, 7KMWCO, 0.5 mL, Product # 89882)
靶标信息
In the intact cell, DNA closely associates with histones and other nuclear proteins to form chromatin. The remodeling of chromatin is a critical component of transcriptional regulation and the acetylation of nucleosomal histones is a major source of this remodeling. Acetylation of lysine residues in the amino terminal tail domain of histone results in an allosteric change in the nucleosomal conformation and an increased accessibility to transcription factors by DNA. Several mammalian proteins function as nuclear histone acetylases, including GCN5, PCAF (p300/CBP-associated factor), p300/CBP, HAT1 and the TFIID subunit TAF II p250. Conversely, the deacetylation of histones is associated with transcriptional silencing. The histone deacetylases (HDAC) include HDAC1-9. HDAC9 and HDAC9a are two alternatively spliced isoforms of HDAC9. HDAC9a is 132 amino acids shorter than HDAC9, but both isoforms contain the HDAC catalytic domain, remain capable of deacetylase activity and repress myoctye enhancer-binding factor 2-mediated transcription. HDAC9 and HDAC9a are expressed in brain, skeletal muscle, kidney, placenta and pancreas.
仅用于科研。不用于诊断过程。未经明确授权不得转售。
篇参考文献 (0)
生物信息学
蛋白别名: DKFZp779K1053; HD7; HD9; hdac-9; histone deacetylase 4/5-related protein; Histone deacetylase 7B; Histone deacetylase 9; Histone deacetylase-related protein; MEF-2 interacting transcription repressor (MITR) protein; MEF2-interacting transcription repressor MITR
基因别名: HD7; HD7b; HD9; HDAC; HDAC7; HDAC7B; HDAC9; HDAC9B; HDAC9FL; HDRP; KIAA0744; MITR
UniProt ID: (Human) Q9UKV0
Entrez Gene ID: (Human) 9734